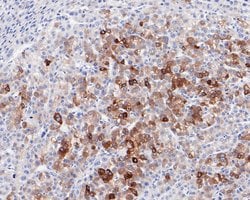
Invitrogen FDFT1 Recombinant Rabbit Monoclonal Antibody (JE60-69) 100 &mu;L;

missing translation for 'onlineSavingsMsg'
Learn More
Learn More
Invitrogen™ FDFT1 Recombinant Rabbit Monoclonal Antibody (JE60-69)


Rabbit Recombinant Monoclonal Antibody
Marke: Invitrogen™ MA544872
Dieser Artikel kann nicht zurückgegeben werden.
Rückgaberichtlinie anzeigen
Beschreibung
FDFT1 Recombinant Monoclonal Antibody for Western Blot, ICC/IF, IHC (P)
FDFT1 catalyzes the first step in the cholesterol biosynthetic pathway, the conversion of trans-farnesyldiphosphate to squalene. The loss of promoter activity and response to sterols for FDFT1 is localized to a 69-bp section positioned 131 bp 5-prime to the transcription start site. Sequence analysis of this region shows that it contains a sterol regulatory element-1 (SRE1) previously identified in other sterol regulated genes and 2 putative NF1 binding sites.
Spezifikation
| FDFT1 | |
| Recombinant Monoclonal | |
| 1 mg/mL | |
| TBS with 0.05% BSA, 40% glycerol and 0.05% sodium azide; pH 7.4 | |
| P37268, P53798, Q02769 | |
| FDFT1 | |
| Recombinant protein within human FDFT1 aa 101-300/417. | |
| 100 μL | |
| Primary | |
| Human, Mouse, Rat | |
| Antibody | |
| IgG |
| Immunohistochemistry (Paraffin), Western Blot, Immunocytochemistry | |
| JE60-69 | |
| Unconjugated | |
| FDFT1 | |
| DGPT; EGK_18680; ERG9; farnesyl diphosphate farnesyl transferase 1; farnesyl diphosphate farnesyltransferase; farnesyl-diphosphate farnesyltransferase; farnesyl-diphosphate farnesyltransferase 1; FDFT1; FPP:FPP farnesyltransferase; presqualene-di-diphosphate synthase; SQS; Squalene synthase; squalene synthetase; SS | |
| Rabbit | |
| Protein A | |
| RUO | |
| 14137, 2222, 29580 | |
| Store at 4°C short term. For long term storage, store at -20°C, avoiding freeze/thaw cycles. | |
| Liquid |
Berichtigung von Produktinhalten
Bitte geben Sie uns Ihr Feedback zu den Produktinhalten, indem Sie das folgende Formular ausfüllen.
Name des Produkts
Haben Sie Verbesserungsvorschläge?Übermitteln Sie eine inhaltliche Korrektur